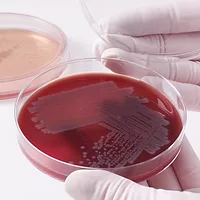
6705InsiderMicroBiologics.jpg

FDA's Lab Accreditation Final Rule: Food Testing Oversight is Finally Here
FDA's final rule on lab accreditation for food testing provides essential directives for quality standards and assurances

Photo credit: yacobchuk/iStock / Getty Images Plus via Getty Images
Today's food laboratories remain largely free of regulatory oversight. That is about to change with the Food and Drug Administration's (FDA's) issuance of a final rule1 establishing a program for the testing of food, in certain circumstances, by accredited laboratories. There should be no delay in the implementation of this well-constructed rule.
Not only does this final rule provide specific quality standards and assurances to a segment of food testing, but it also opens the door for all laboratories to adhere to these essential elements. FDA said as much in the final rule: "We expect that creating model laboratory standards based on ISO/IEC [International Organization for Standardization/International Electrotechnical Commission] 17025:2017 accreditation may encourage other laboratories to work toward these standards, including accreditation."
The agency teased the possibility of future rulemaking to expand the scope of oversight. The final rule suggests that FDA may require "additional specific follow-up testing" in accordance with the Food, Drug, and Cosmetic Act regulations. If an expanded scope were pursued, then FDA would go through another notice-and-comment rulemaking, but it would still use the testing processes established in this final rule.
For all of these reasons, this final rule is a notable achievement for food safety and advocates of quality food laboratory testing. As stated by the Food Laboratory Alliance, a coalition of organizations supporting this mission, "The goal is not—and could not be—to test all food. The goal should be that all testing of food should be reliable and accurate."
Limited Scope
Before examining the details of how this oversight program will proceed, it is important to understand when food testing falls under its jurisdiction. All of the following testing scenarios exist already, but now they will be subject to the final rule requirements for laboratory testing:
- If a food product or environment must be tested to address an identified or suspected food safety problem, then FDA may direct a food laboratory order. Through this order, the FDA will specify what is tested, under what time frame, and the manner and method of testing to be conducted.
- In administrative procedural settings when an identified or suspected food safety problem is presented to the FDA (1) as part of evidence for a hearing prior to the issuance of a mandatory food recall order, (2) as part of a corrective action plan submitted after an order suspending the registration of a food facility, or (3) as part of evidence submitted for an appeal of an administrative detention.
- To support the admission of an article of imported food.
- To support the removal of food from an import alert through successful consecutive testing.
- In response to explicit testing requirements that address an identified or suspected food safety problem with sprouts, shell eggs, and bottled drinking water. For shell eggs, the requirement applies to farms with more than 3,000 laying hens. For bottled drinking water, five samples from the same sampling site must be tested if they originally tested positive for the pathogen Escherichia coli.
Food Testing Infrastructure
Effective February 1, 2022, the final rule establishes a structure to which food laboratories must adhere if they want to conduct testing for FDA-directed purposes. It is a voluntary program, but if laboratories choose to perform the testing, they must adhere to the requirements of the final rule.
In a nutshell, any person with an ownership or consignment interest in a food product or its food testing environment may choose to have its food sample tested for an FDA-specified purpose. If the owner or consignee chooses to have its product or environment tested, then it must use a laboratory that has been accredited through laboratory accreditation for analyses of foods (LAAF) accreditation.
Looking for quick answers on food safety topics?
Try Ask FSM, our new smart AI search tool.
Ask FSM →
FDA outlines the LAAF program in four tiers. First, the agency will review applications and grant recognition to select accreditation bodies that meet its criteria. With this FDA recognition, the accreditation body may begin assessing laboratories for LAAF accreditation. Second, if a laboratory meets the accreditation requirements, it becomes designated as a LAAF-accredited laboratory. Once this is accomplished, the LAAF-accredited laboratory may conduct food testing as specified by FDA. Finally, in tier four, the food testing results and accompanying information are submitted to FDA for review.
Accreditation Bodies
Accreditation bodies must meet several criteria for FDA to recognize and authorize them to LAAF-accredit laboratories. One requirement is that an accreditation body must demonstrate its compliance with international standard ISO/IEC 17011:2017 and be a full member of the International Laboratory Accreditation Cooperative (ILAC), as well as a signatory to the ILAC Mutual Recognition Arrangement. An eligible accreditation body must also ensure that it does not own, have a financial interest in, manage, or otherwise control any laboratory it LAAF-accredits, among other impartiality provisions. A recognized accreditation body must audit its compliance with these requirements.
Among its responsibilities, a recognized accreditation body must conduct onsite assessments of a laboratory seeking LAAF accreditation to determine if it is capable of conducting each method of food testing. The recognized accreditation body continues to oversee the performance of the laboratory it accredits to LAAF to ensure its continued compliance with quality testing requirements.
Quality Standards for LAAF-Accredited Laboratories
A laboratory that is LAAF-accredited must demonstrate its capability of conducting each stated method of food testing. The baseline requirement for LAAF accreditation is adherence to international standard ISO/IEC 17025:2017. FDA notes that this standard, along with the accreditation body standard ISO/IEC 17011:2017, are "the most appropriate globally recognized and widely used standards."
In addition, laboratories must successfully pass a proficiency test every 12 months for each testing method within its LAAF accreditation scope. Proficiency testing is used to assist laboratories in verifying that their performance of each test is comparable with others performing the same analysis. It is an objective means of assessing analytical performance and documenting quality assurance. The final rule acknowledges "the critical role that proficiency testing plays" in the LAAF program.
If no proficiency testing program is available for the test method, then an approved comparison program may be used. All proficiency testing and comparison program results, regardless of their outcome, must be sent to the recognized accreditation body within 30 calendar days of receipt.
Procedures for monitoring the validity of test results must include the use of reference materials or quality control samples with each batch of samples tested. FDA notes that these tools are "vital to a laboratory's demonstration of capability to conduct a method."
As noted by the Food Laboratory Alliance, "It is essential for all laboratories that test food to follow appropriate standards to ensure accurate and reliable test results, ultimately providing for the betterment of public health and a stronger commerce system."
LAAF-accredited laboratories that conduct analyses of food samples are responsible for submitting all results, reports, studies, and notifications to FDA. The final rule details what information must accompany full analytical reporting. This includes name and street address; all sampling plans and sample collection reports, validation, and verification studies (as required); calculations; identification of software used; certificate of analysis; qualifications of the analysts performing the analysis; and identification of the source and purity of reference standards, among other requirements. If FDA does not receive all required information, then the related food testing may be considered invalid.
With FDA's permission, LAAF-accredited laboratories may submit an abridged analytical report for each major food testing discipline. Disciplines are categorized as biological, chemical, or physical. Permission will be granted if the last five full analytical reports for the discipline contain no administrative errors or shortcomings in validity and if the LAAF-accredited laboratory has successfully implemented any required corrective actions. The LAAF-accredited laboratory must also be clear of suspension or probation.
Even LAAF-accredited laboratories that receive permission to file an abridged analytical report may be required to submit a full analytical report if the matter warrants it. This may refer to an enforcement proceeding, FDA investigation, audit, or for public health purposes.
Sampling
Before analyzing a sample, an LAAF-accredited laboratory must develop or obtain certain information to accompany the test results. Written documentation of a sampler's applicable qualifications, sampling plan, and a collection report for each sample collected is required.
Testing may be conducted by any LAAF-accredited laboratory, regardless of location. Unless FDA has granted an exception, however, the sampling of an import must occur after its arrival on U.S. soil.
Public Registry
Names and contact details of recognized accreditation bodies and LAAF-accredited laboratories will appear on a public FDA website. This is intended to provide food owners and consignees with easy access to available LAAF resources.
Implementation
While the final rule became effective on February 1, 2022, the implementation will occur in methodical stages. FDA intends to first onboard accreditation bodies and recognize officially those passing the eligibility criteria. Next, those recognized accreditation bodies will begin LAAF-accrediting laboratories. Once a sufficient number of laboratories are LAAF accredited, the FDA will give owners and consignees six months before they are required to use them.
The timeline for accomplishing these steps was not announced; however, implementation should not be delayed. Accuracy and reliability in food testing are too important.
Reference
- U.S. Food and Drug Administration, Department of Health and Human Services. "21 CFR Parts 1, 11, 16, and 129: Laboratory Accreditation for Analyses of Foods." Federal Register 86, No. 230 (December 3, 2021). https://www.govinfo.gov/content/pkg/FR-2021-12-03/pdf/2021-25716.pdf.
Robin E. Stombler is President of Auburn Health Strategies LLC, a strategic and business development firm representing health and science organizations. She serves as Vice Chair of the Board of Directors for the American Association for Laboratory Accreditation (A2LA), and also established and directed the Food Laboratory Alliance.